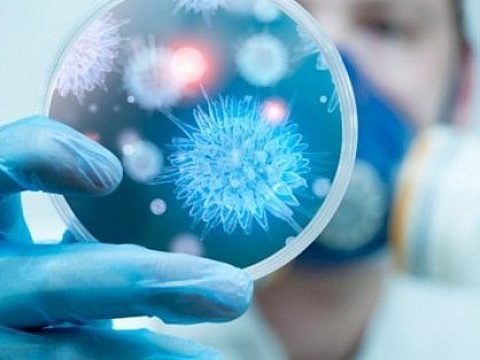
Що треба знати про поліомієліт!

Що треба знати про поліомієліт!
Поліомієліт – це гостре інфекційне захворювання, що уражує нервову систему і викликає повний параліч. Поліовірус поширюється від людини до людини через фекалії та слину, найчастіше - через брудні руки, заражену їжу та воду. Симптоми захворювання: висока температура, втома, головний біль, нудота, регидність шиї та біль у кінцівках. Найбільш сприйнятливі до вірусу поліомієліту діти у віці до 5 років. Саме тому важливе значення має своєчасна вакцинація. Близько 5% хворих помирають через порушення дихання при паралічі дихальної мускулатури. У одного з 200 хворих розвиваються деформації хребта і кінцівок, що стають причиною інвалідності. Інші небезпечні ускладнення поліомієліту – пневмонія, міокардит, важкі шлунково кишкові розлади з кровотечею, проривом, виразками, кишкова непрохідність. Поліовірус стійкий в навколишньому середовищі. Він зберігає свої інфекційні властивості в стічних водах при 0°С протягом місяця. Нагрівання при температурі 50°С вбиває вірус протягом 30…









